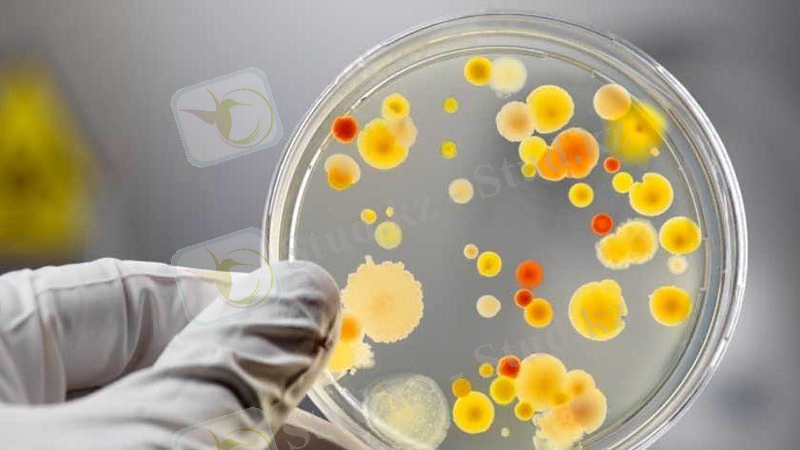

Микробтардың паразитизмі: эволюция және патогендік микроорганизмдердің шығу тегі


Марат Оспанов атындағы Батыс Қазақстан Мемлекеттік Медицина Университеті

Студенттің өзіндік жұмысы
Мамандық: Жалпы медицина
Кафедра: Микробиология және вирусология, имуннология
Дисциплина: Микробиология
Курс: II
Тобы: 207 Б
Тақырыбы: Микробтың паразитизмнің эволюциясы және патогендік микроорганизмдердің шығу тегі.
Орындау түрі: мәнжазба
Орындаған: Тәжіғос А. Т.
Тексерген: Кеулімжаева А. Е.
Ақтөбе 2016
Жоспары
І. Кіріспе.
ІІ. Негізгі болім.
А. Патогенді микробтар туралы жалпы түсінік.
Б. Патогенді микробтардың қасиеттері.
В. Микроорганизмдің инфекциялық процестегі рөлі.
ІІІ. Қорытынды.
Адамдардын, жануарлардың немесе өсімдіктердің макроорганизмі үшін патогендік дәрежесіне карай барлык микробтарды топқа бөледі; патогенді, сапрофитті және шартты-потогенді.

Патогенділер - бұл адамдардын, жануарлар мен өсімдіктердің жұқпалы ауруларының қоздырғыштары. Эволюция барысында патогенді микробтардын адаптациялануының тереңдегені сонша, олар белгілі бір уақытта макроорганизммен тыс жағдайда бола алатынына қарамастан, микроорганизімде тіршілік етуі микробтың биологиялық түр ретінде сақталуына қажетті шарт болып табылады. Осыған орай, үшін ауру- бұл эволюция барысында макроорганизмен симбионттық қатынас қалыптасуының нәтижесі болып табылады.
Сапрофиттер немесе патогенсіздер - бұл өсімдіктердің және жауарлардың өлі тіндермен немесе олардың тіршілік ету кезіндегі өнімдермен қоректенетін микробтар. Әрбір түрлердің қоректік субстраттарға талғамдық дәрежесі әртүрлі болады. Олар макроорганизмге байланысты емес, оларға тек қана дайын органикалық заттар қажет.
Кейбір микробтар, мысалы, күйдіргі және сіреспе қоздырғыштары топырақта сапрофиттер ретінде тіршілік етеді. Метаболиттер көзі және тіршілік ету ортасы ретінде пайдалану үшін макроорганизмге енгеннен кейін олардың патогенділігі көріне бастайды.
Шартты-патогенділер бұл- организге тиісті жағдайда, яғни макроорганизмнің резистентілігі күрт төмендеп, көп мөлшерде микроорганизмнің ішкі ортасына түскенде ауру туғызушылық әсер ететін микробтар. Олар патогенді микробтар мен сопрофиттердің аралық жағдайында орын алады. Шартты патогенді микробтарға адамдардың қалыпты микрофлорасының өкілдері немесе жұқпалы аурулар тудыра алатын еркін өмір сүруші микробтар жатады.
Патогенді микробтар - ұзақ мерзімді қатал эволюциялық даму барысында сапрофиттерден пайда болған паразиттер. Бұл кезде олар ферменттік жүйелерінің бірқатарын жоғалтқан. Өйткені көптеген заттарды дайын түрінде макроорганизм береді. Олар әртүрлі органдарда, тіндерде және жасушаларда гетеротрофты паразиттік қоректену типіне бейімделген. Жасушаішілік паразиттік тіршілік ету қабілеттілігіне қарай осындай микробтарды топқа бөлуге болады; жасуша ішілік облигатты паразиттер, жасушаішілік факултативті паразиттер және жасушадан тыстық облигатты паразиттер.
Облигатты жасушаішілік паразиттер өзінің қоректік қажеттілігін тек қана жасушаішілік тіршілік ету жағдайында қанағаттандырады. Әрине жасушаішілік ортаның жасушадан тыс ортадан көптеген физикалық- химиялық қасиеттері бойынша айырмашылығы бар екенін, бұл орта жасушадан тыс жағдайда тіптен болмайтын органикалық заттарға, АТФ-қа бай. Мұндай ортада тіршілік етуге қажетті дайын заттар көп, ақуыз синтездеуші жүйе бар. Жасуша микробтардың метаболизмдік, энергетикалық, генетикалық және ақуыз синтездеушілік қажеттілігін қамтамасыз етумен қатар, оларды жасуша мембранасы арқылы өтпейтін, антиденелердің, фагоциттердің, бактериофактардың және антибиотиктердің әсерінен қорғайды. Жасушаішілік паразиттер жасуша ішінде сақталуға және өсіп-өнуге жақсы бейімделген. Жасушаішілік инфекция дамуында нысана- жасуша макрофактар болып табылады, мұндай рөлді жасушалар атқаруы мумкін. Бұл макрофактардың микробтарды белсенді түрде жұтып сіңіру қабілеттілігімен байланысты, ал микробтар өз кезегінде аяқталған фагоцитоздан қорғайтын механизмге ие болған. Облигатты жасуша ішілік паразитттерге вирустар, рикетсиялар, хламидиялар алапес, безгек, токсаплазмоз, қоздырғыштары жатады. Жасанды қоректік орталарда өсіп өнбейді.
Факультативті жасушаішілік паразиттер жасуша ішінде де және жасушадан тыс жағдайда да тіршілік ете алады. Иә, организмге жасуша ішілік өсіп өну олар үшін басымырақ болады, әйтсе де олар жасушадан тыс жағдайда өсіп өніп көбейе алады. Өйткені организм жағдайындағы жасуша ішілік орта инфекциялық процесс дамуында негізгі орын болып табылады. Жасуша ішілік паразиттік олар, макроорганизмде микробтардын тірі қалуын және сақталуын жеңілдетеді мұндай микробтар қоректік орталарда өсіп өне алады. Оларға туберкулез, туляремия, соз, минингококкты инфекция қоздырғыштары, солмонелар, шигеллар және басқа микробтар жатады. Облигатты жасудан тыс паразиттер- жасуша ішіне кірмейтін, бірақ жасушалар бетіне жабысып, жасушааралық қуыстармен, таралатын микробтар. Мысалы, мұндай микробтарға қоздырғышы, лептоспиралар, микоплазмалар және т. б микробтар жатады. Жасушадан тыстық паразиттердің агрессиялық және инвазиялық икзоферменттер өндіріу қабілеттілігі болады.
Патогенділік - микробтардың инфекциялық процесс қоздырушы потенциялық қабілеттігі, яғни осы микроб үшін табиғи жұғу жағдайында организміне ену, онда өсіп өніп көбею, гоместаздардын әртүрлі бұзылыстарын туғызу және макроорганизм жағынан жауап ретінде қарсы реакциялар қоздыру қабілеттілігі.
Паразитизм
(грек. Parasites-арамтамақ) ағза бөгде ағзаның денесінде тіршілік етіп оған зиянын тигізеді. Паразиттерге-вирустар, приондар, бактериялар, саңырауқұлақтар, қарапайымдылар, құрттар-гельминті.
Адамда және жануарларда ауру туғызатын микроорганизмдер (грек. pathos-қайғы, қасірет, genos-туылу) ал олардың ауру туғызуы-патогендік деп аталады. Адамға қауіпті 2500 инфекциялық аурулар түрлері белгілі.
Инфекциялық сөзі лат. «infectio» -жұғу, жұқтыру деген мағынаны білдіреді.
Қазіргі кезде адам организмдерімен потагенді микробтар арасындағы қарым-қатынасты 3түрлі терминдермен қарастырады: инфекция, инфекциялық процесс, инфекциялық ауру.
Инфекция термині эволюциялық процесс кезінде адам ағзасы-микроорганизм және қоздырушы микроорганизм арасындағы биологиялық қарым-қатынасты атайды. Инфекциялық процесс термині микроорганизмдегі патогенді микробтарға қойылатын қарсы әрекетін білдіреді. Инфекциялық ауру-инфекциялық процестің клиникалық өзгешелігі, әр түрлі симптомдар және признактармен көрінеді.
Патогенді микробтардың қасиеттері
Патогенділікті ие макроорганизміне микробтың бейімделу функциясы деп қарастыру ұсынылған, мұның негізінде жаңа жағдайда адекватты тіршілікетуі үшін микроб метаболизмінің қайтадан икемделуі жатыр. Тәжірибелі жағдайда жоғарғы вирулетті микробтардың тиісті дозасын пайдаланғанда кез-келген микроб, кез-келген тәсілмен жұқтырғанда инфекциялық процесс қоздыра алады.
Патогенділік факторлары-ол микробтардың инфекциялық процесс қоздыру қабілеттілігін қамтамсыз ететін материалдық зат тектер. Патогенділік факторларды зерделеу патогенді микробтардың патогенсіздерден және қабылдағыш макроорганизмнің қабылдамайтынынан қандай айырмашылықтары бар екенін түсінуге мүмкіндік береді. Сапрофиттерге қарағанда патогенді микробтар макроорганизмнің табиғи тосқауылдарын жеңуі және сол организде тіршілік етуі үшін адгезиялық, колонизациялық және инвазиялық қасиетке ие болуа керек, яғни макроорганизмнің қорғаныс тосқауылдарын бұзып өту, инфекцияның кіру есігінен тысқары жерде макроорганизмнің ішкі ортасыеа ену және тіндерде таралу, макроорганизмнің жасушасы ішіне енуі қабілеттілігі болу керек. Сонымен қатар агрессивтік, яғни макроорганизмнің қорғаныс факторларымен интерфериенцмяланатын агрессиндердің көмегімен организмнің бейспецификалық және спецификалық реактивтілігін басыа тастайтын, соның ішінде фагоцитозға қарсы тұру қабілеттілігі болу керек.
Макроорганизмде сақталу және өсіп-өніп көбею мағынасын қамтитын инвазивтік терминді қазіргі кезде стафилококтар, стрептококтар, псевдомонолар т. б. жасушадан тыстық паразиттер үшін қолданылады. Патогенді микробтар микроорнанизмге улық әсер етуі керек. Патогенді микробтар осы функциялардың әр қайсысын, макромолекулалардан тұратын, инфекциялық процестің спецификалығын қамтамасыз ететін патогенділік факторларды сақтаушы арнайы құрылымдардың көмегімен іске асырады. Спецификалық қасиет әсер етуші құрылымдардың өзара бойынша биологиялық тану механизміне негізделген. Адгезиялануды, колонизациялануды және фагоцитоздан қорғануды негізінде микробтардың беткейлік морфологиялық құрылымының құрамына кіретін макромолекулалар іске асырады. Инвазиялық және адгезиялық қасиет негізінде экзофрменттердің, ал улық әсер ету-жұқпалы аурулар кезіндегі спецификалық симптомдардың дамуында жетекші рөл атқаратын, токсиндердің әсер етуімен байланысты. Инфекциялық процестің процестің тиісті сатыларының дамуында бірден бірнеше патогенділік факторлары қатысады.
Патогенді микробтар тері және шырышты қабықтың бетінде орнығып қалуы үшін макроорганизмнің табиғи қорғаныс тосқауылдарын белсенді түрде жеңіп алуға тырысады. Микробтардың микроорганизмде жайылып таралу және оның қорғаныс факторларына қарсы тұру қабілеттілігі микробтар түзетін ферменттермен байланысты, ол әсіресе жасушадан тыстық облигатты паразиттерге тән. Ферменттер әрі жеткілікті, әрі кең жайылып әсер ете алады. Олар токсиндердің әсерін күшейтіп және де протоксиндерді токсинге айналдырып жасушалларды және тіндердің талшықтарын бұзады немесе микроорганизм үшін улы заттар пайда болуы нәтижесінде өздері токсин түрінде әсер етеді.
Фагоциттерге қарсы белсенділігі бар бактериялар мен басқа да микробтардың маңызды патогенділік факторларына капсулалар, микрокапсулалар, шырышты қаптамалар және олардың құрамына кіретін антигендер жатады. Олар микробтың беткейлік құрылымдардың көлеңкелеп механикалық тосқауыл рөлін атқарады. Бұл құрылымдар, микробтардың молекуласын танушы және оларды фагоциттеуші жасушалармен байланыстыратын лигандтар рөлін орындаушы опсониндермен өзара әсерлесіп және де фагоциттеуші жасушалардың рецепторларымен тікелей әрекеттесіп микробтарды тануға және оларды қоршап жұтуға кедергі жасайды. Капсулалық заттар микробтарды лизосомальдық ферменттердің және фагоциттеуші жасушалардың асқынтотықтық радикалдарынан қорғайды. Капсула және кіллегейлі микробтардың сыртынан жеңіл ажырауы фагоциттеуші жасушалардың рецепторларымен жалған байланысуға әкеледі. Микробтардың капсулалық варианттары, әдетте, олардың капсуласыз варианттарына қарағанда ауыр түрде өтетін кесел қоздырады.
Микробтардың фагоцитоздық барлық сатысында фагоциттеуші белсенділігін басып тастай алады. Микробтардың фагоциттерге қарсы әсер ету қасиеті тек қана оларда капсула, микрокапсула және шырышты қаптамаларының болуымен емес және де микробтардың басқа да қасиеттерімен байланысты; фагоциттеуші жасушалардың хемотаксисін басып тастайтын, хемоаттрактанттар мен фагоциттеуші жасушаларды бұзатын заттар шығады, лизосоманың фагосомамен бірігуіне кедергі
жасап, жасушаішілік қорытылуға қарсы тұрады; оттегі тәуелді киллерлік тиімділік беретін асқын тотық радикалдарының белсенділігін жоятын ферменттер түзеді; лизосомальдық ферментттерге төзімділік пайда болады; фаголизосомалардың лизистенуін туғызатын заттар бөліп шығарады; фаголизосомаларды тастап кетеді; фагоциттеуші жасушалардың апоптозын индуцирлейді. Екінші жағынан, жасушаішілік облигатты паразиттер хемотаксисті күшейтетін және жасушалардың фагоциттеуші белсенділігін арттыратын заттар шығарады, ол микробтардың жасуша ішіне енуін жеңілдетеді. Сонымен, микробтардың жасушаішілік тіршілік ету және аяқталмаған фагоцитоздың механизмдері әр алуан.

Инфекциялық аурулардың таралуы
Инкубациялық кезең -
ауруды жұқтырғаннан бастап клиникалық белгілерінің шығуына дейінгі уақыт.
Продромальдік кезең- ең алғашқы клиникалық белгілердің көрінуі. Аурудың асқынған кезеңі-аурудың кезеңі.
Реконвалесценттік кезең- симптомдардың жойылып, аурудың жазылу кезеңі.
Бактерия тасушы- ағзадағы патогенді микробтар ауаға, айналаға тарап, бірақ организм клеткасын зақымдайды. Тасымалдаушының қауіпті кезеңі-ауру организмде 3ай сақталса хронический-ұзақ уақытқа созылады.
Инфекциялық аурудың жұғуы-ауру адамнан қоздырғыштар сау адамға жұғуы. Ауру тез шалдыққыш ағзада инфекциялық аурулар жұғушы қасиетін көбейтеді.
Инфекциялық аурулардың таралу деңгейін 5топқа бөледі:
1. Ең жиі таралған аурулар (1 000 000 халыққа 1 000 оқиға) -тұмау, ОРВИ
2. Кең таралғандар (1 000 000 халыққа 100 оқиға) -вирустік гипотит А, жедел ішек инфекциялар, қызылша, қарамық т. б.
3. Жиі кездесетіндер (1 000 000 халыққа 10 оқиға) -көк жөтел, вирустік гипотит В.
4. Сирек кездесетіндер (1 000 000 халыққа 1-10 оқиға) -бруцеллез.
5. Өте сирек кездесетіндер (1 00 000 адамға 1 оқиға) -дифтерия, құтыру, сібір жарасы т. б.

МИКРООРГАНИЗМДЕРДІҢ ИНФЕКЦИЯЛЫҚ ПРОЦЕССТЕГІ РӨЛІ.
- Іс жүргізу
- Автоматтандыру, Техника
- Алғашқы әскери дайындық
- Астрономия
- Ауыл шаруашылығы
- Банк ісі
- Бизнесті бағалау
- Биология
- Бухгалтерлік іс
- Валеология
- Ветеринария
- География
- Геология, Геофизика, Геодезия
- Дін
- Ет, сүт, шарап өнімдері
- Жалпы тарих
- Жер кадастрі, Жылжымайтын мүлік
- Журналистика
- Информатика
- Кеден ісі
- Маркетинг
- Математика, Геометрия
- Медицина
- Мемлекеттік басқару
- Менеджмент
- Мұнай, Газ
- Мұрағат ісі
- Мәдениеттану
- ОБЖ (Основы безопасности жизнедеятельности)
- Педагогика
- Полиграфия
- Психология
- Салық
- Саясаттану
- Сақтандыру
- Сертификаттау, стандарттау
- Социология, Демография
- Спорт
- Статистика
- Тілтану, Филология
- Тарихи тұлғалар
- Тау-кен ісі
- Транспорт
- Туризм
- Физика
- Философия
- Халықаралық қатынастар
- Химия
- Экология, Қоршаған ортаны қорғау
- Экономика
- Экономикалық география
- Электротехника
- Қазақстан тарихы
- Қаржы
- Құрылыс
- Құқық, Криминалистика
- Әдебиет
- Өнер, музыка
- Өнеркәсіп, Өндіріс
Қазақ тілінде жазылған рефераттар, курстық жұмыстар, дипломдық жұмыстар бойынша біздің қор #1 болып табылады.



Ақпарат
Қосымша
Email: info@stud.kz